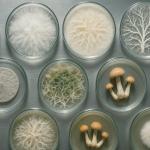

Durante décadas, la historia de la vida terrestre se contó empezando por las plantas: aquellas pioneras verdes que colonizaron los continentes y dieron origen a los ecosistemas que hoy conocemos. Pero una nueva investigación publicada en Nature Ecology & Evolution acaba de poner esa cronología patas arriba. Según un equipo internacional de científicos, los hongos surgieron y se diversificaron casi mil millones de años atrás, mucho antes de que existieran los primeros árboles o helechos.
Este hallazgo no solo cambia las fechas: reescribe el papel que los hongos jugaron en los orígenes de la vida terrestre. Los investigadores sugieren que estos organismos no esperaron a las plantas para salir del agua, sino que lo hicieron antes, de la mano de algas microscópicas. Juntos, habrían formado los primeros suelos y creado las condiciones necesarias para que la Tierra se volviera un lugar habitable. Los hongos fueron los verdaderos arquitectos del planeta vivo.
El estudio, liderado por el biólogo evolutivo Lénárd L. Szánthó junto a un equipo de instituciones europeas, utilizó una combinación inédita de fósiles, relojes moleculares y un recurso casi detectivesco: los rastros de genes “prestados” entre especies antiguas. Con esa información, los científicos pudieron reconstruir el árbol evolutivo de los hongos con una precisión nunca antes alcanzada.

El reino invisible que lo cambió todo
Aunque los hongos están por todas partes —en el pan, el suelo, los bosques o nuestro propio cuerpo— su historia es de las más difíciles de rastrear. No dejan esqueletos ni conchas, y sus cuerpos blandos rara vez se conservan como fósiles. Por eso, durante mucho tiempo se creyó que habían aparecido junto con las plantas, hace unos 500 millones de años. Pero el nuevo estudio demostró que su linaje es mucho más antiguo: entre 1.4 y 0.9 mil millones de años de antigüedad, cuando la Tierra era aún un mundo dominado por microbios y mares primitivos.
Esta edad coincide con un momento clave de la historia del planeta: el surgimiento de los primeros organismos multicelulares complejos, entre ellos animales, algas y hongos. A diferencia de los animales o las plantas, los hongos no fabrican su propio alimento ni lo cazan; lo absorben del entorno, descomponiendo materia orgánica o estableciendo relaciones de intercambio con otros seres vivos.
Esa habilidad química y ecológica los convierte en los recicladores originales del planeta, capaces de liberar nutrientes que otros organismos no podían aprovechar.
Los científicos creen que fue esa capacidad la que permitió a los hongos aliarse con algas ancestrales, formando las primeras asociaciones simbióticas en tierra firme. De esa unión surgirían los precursores de lo que hoy conocemos como líquenes y micorrizas, asociaciones vitales para las plantas. Antes de que existieran los bosques, ya había hongos trabajando bajo la superficie.
Un reloj genético para medir lo invisible
¿Cómo se puede datar algo que apenas deja fósiles? El equipo de Szánthó recurrió a la biología molecular. Cada especie acumula pequeñas mutaciones en su ADN con el paso del tiempo, como si fueran las marcas de un reloj que nunca se detiene. Comparando los genes de 110 especies de hongos con los de otros organismos eucariotas, los investigadores pudieron calcular cuándo divergieron de sus ancestros comunes.
El problema es que ese reloj genético no tiene calendario: solo marca intervalos relativos. Para transformarlo en fechas reales se necesitan puntos de referencia, y los fósiles fúngicos son escasos.
Aquí entra en juego la innovación del estudio: los científicos aprovecharon algo llamado transferencias horizontales de genes (HGT), pequeños episodios en los que un gen “salta” de una especie a otra sin pasar por la herencia tradicional.
Estos saltos genéticos funcionan como pistas temporales: si una especie A transfirió un gen a una especie B, se sabe que A existía antes que B. Con 17 de estos “intercambios genéticos” identificados entre antiguos hongos, los investigadores pudieron establecer una secuencia de eventos evolutivos más sólida y precisa. Los genes que cruzaron fronteras sirvieron como las agujas del reloj más antiguo del mundo.

Los hongos que prepararon el terreno para la vida
El resultado de ese análisis pinta un panorama fascinante. Mientras el mundo era aún un paisaje rocoso y sin plantas, los hongos ya estaban allí, creciendo junto a algas y bacterias en los bordes húmedos de la tierra. Con sus enzimas, disolvían minerales y descomponían la roca, liberando nutrientes y generando las primeras capas de suelo fértil.
Durante cientos de millones de años, estas diminutas alianzas bioquímicas transformaron un planeta inhóspito en un entorno capaz de sostener ecosistemas más complejos.
Cuando finalmente aparecieron las plantas, encontraron un mundo ya preparado: con suelos ricos, microbios simbióticos y redes subterráneas que favorecían su crecimiento. Las plantas no conquistaron un desierto, sino un mundo previamente moldeado por los hongos.
El estudio incluso estima que las primeras interacciones entre hongos y algas ocurrieron hace entre 1,253 y 797 millones de años, mucho antes de la aparición de los primeros helechos o árboles. Esta larga “prehistoria verde” fue el laboratorio donde se ensayaron las alianzas que más tarde dominarían los ecosistemas terrestres.
El arte de reconstruir el pasado sin fósiles
El trabajo fue posible gracias a un esfuerzo colaborativo que reunió a especialistas en paleontología, genómica y biología evolutiva de varias instituciones europeas, incluyendo la Universidad de Bristol, el Barcelona Supercomputing Centre y el Instituto de Ciencia y Tecnología de Okinawa (OIST). Juntos, crearon una base de datos con 225 marcadores genéticos y modelos matemáticos capaces de estimar fechas evolutivas con una precisión inédita.
Para resolver las incógnitas más difíciles, los investigadores usaron diferentes “versiones” del reloj molecular, comparando los resultados con y sin ciertos tipos de calibraciones fósiles o genéticas. Así pudieron descartar hipótesis y validar la consistencia de sus estimaciones.
Las fechas obtenidas no son un número fijo, sino un rango que refleja la incertidumbre natural de trabajar con eventos ocurridos hace más de mil millones de años.
Aun así, todas las líneas de evidencia apuntan en la misma dirección: los hongos son más antiguos, más resilientes y más influyentes de lo que se pensaba. En ese sentido, el trabajo no solo corrige el calendario evolutivo, sino que reivindica a los hongos como protagonistas olvidados de la historia de la vida.

Los primeros ingenieros del planeta
Si pensamos en ingeniería ecológica, solemos imaginar a los árboles capturando carbono o a los corales construyendo arrecifes. Pero mucho antes de todo eso, fueron los hongos quienes diseñaron las primeras arquitecturas de la biosfera. Sus redes subterráneas —precursoras de las actuales micorrizas— conectaban organismos, reciclaban nutrientes y mantenían la estabilidad de los primeros suelos.
Esta investigación propone que la vida terrestre no comenzó con las plantas, sino con una cooperación microscópica entre hongos y algas. Ese pacto primitivo habría transformado la química del planeta, haciendo posible la aparición posterior de ecosistemas complejos. Sin ellos, la Tierra habría tardado mucho más en volverse habitable.
Hoy, cuando hablamos de sostenibilidad, cambio climático o suelos degradados, los hongos siguen siendo aliados indispensables. Este estudio no solo ilumina su pasado, sino que nos recuerda una verdad fundamental: sin los hongos, el planeta no habría sido, ni sería, el mismo.
Referencias
- Szánthó, L.L., Merényi, Z., Donoghue, P. et al. A timetree of Fungi dated with fossils and horizontal gene transfers. Nat Ecol Evol (2025). doi: 10.1038/s41559-025-02851-z